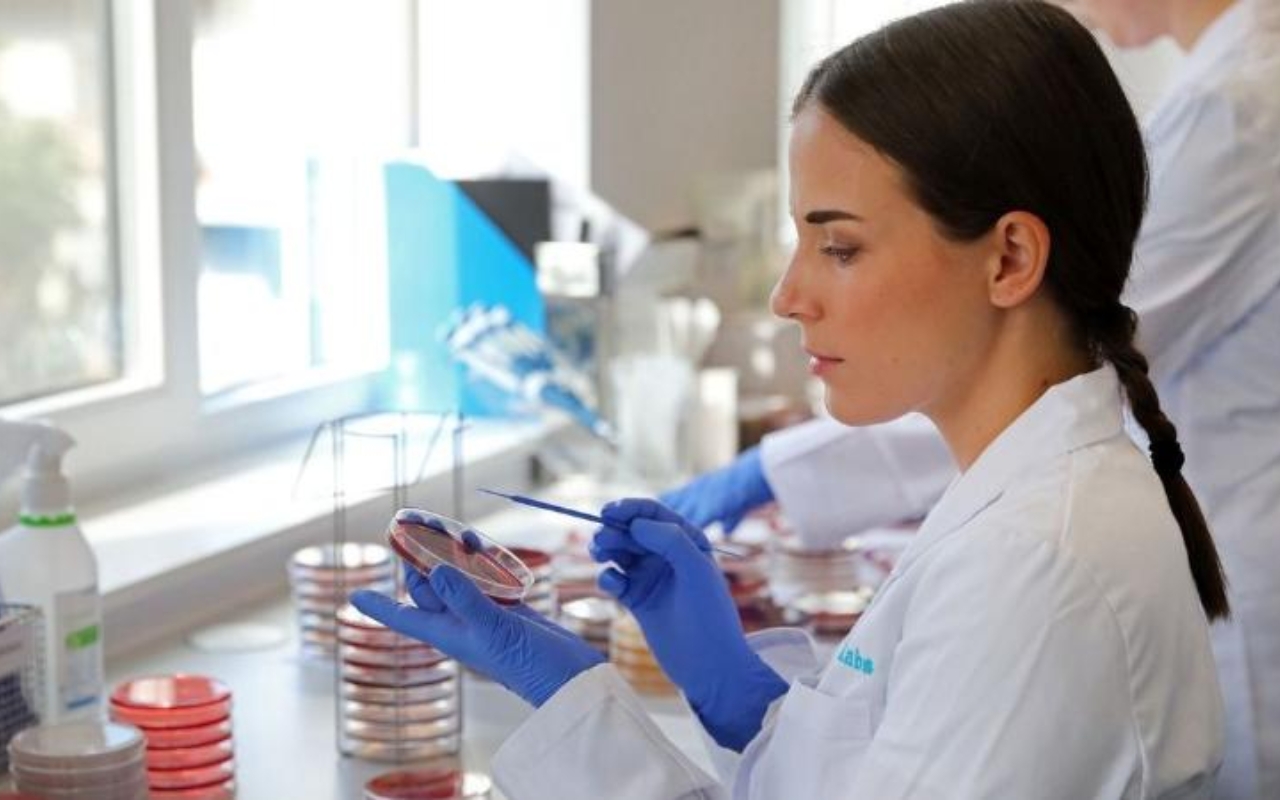

Agyvelőgyulladásos beteget azonosítottak Hajdú-Biharban
Egy agyvelőgyulladásos beteget is azonosítottak Hajdú-Bihar vármegye területén – derül ki a Nemzeti Népegészségügyi és Gyógyszerészeti Központ friss járványügyi jelentéséből.
Egy agyvelőgyulladásos beteget is azonosítottak Hajdú-Bihar vármegye területén – derül ki a Nemzeti Népegészségügyi és Gyógyszerészeti Központ friss járványügyi jelentéséből. A hatóság szerint összességében kedvező a hazai helyzet: a legtöbb fertőző betegségből kevesebb esetet regisztráltak, mint egy héttel korábban, és tömeges járványt sem jelentettek. Hajdú-Biharban ugyanakkor több megbetegedést is kimutattak: hat salmonellás fertőzést, huszonegy rotavírusos esetet, továbbá skarlátot és bárányhimlőt is. A súlyosabb esetek között egy vírusos májgyulladás, egy savós agyhártyagyulladás és egy agyvelőgyulladás szerepel. A szakemberek továbbra is a higiéniai szabályok betartását és a tünetek korai felismerését hangsúlyozzák.
Fotó: freepik.com



































